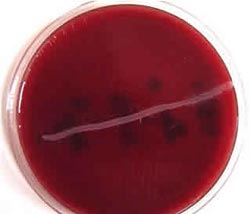

Descripción de la granja
Se trata de una explotación situada en Francia de ciclo cerrado con 800 madres, con manejo en 2 sitios con una distancia de 100 metros entre ambos:
- Sitio 1: desde nacimiento hasta destete a los 21 días de vida más 19 días post-destete (edad de los animales a la salida= 40 días). Preparación de las primerizas F1 (de auto reemplazo) en el sitio de nacimiento.
- Sitio 2: Pre-engorde y engorde.
Aparición del problema
El productor avisa al veterinario tras observar los siguientes problemas respiratorios crónicos:

- Presencia desde hace 1 año de tos crónica en los cerdos destetados y sobretodo en los cerdos de engorde.
- Disnea en el engorde.
- Bajo rendimiento de los animales: GMD de 700 g/d cuando el valor objetivo es de 800 g/d.
- Recaída sistemática después de cada tratamiento.
- Aislamientos bacterianos diferentes si se presentan casos de brotes respiratorios: Pasteurelas, Haemophilus, Estreptococos y Micoplasmas.
- Controles anteriores en los mataderos: nota global de los pulmones observados = 1/28
La explotación se controla regularmente para presencia de la enfermedad de Aujeszky y de PRRS siendo negativa para ambos.
![]() |
![]() |
![]() |
|
Exámenes antes de la visita
Se piden datos del control de los animales en matadero para un lote de cerdos (mínimo 100) y un lote de primerizas F1 (mínimo 30).
Resultados de los cerdos:
-
- % de pulmones afectados: 15 %
- Puntuación para neumonía en pulmones afectados: 5,5/28
- Puntuación global : 0,82/28
- % de pleuresías : 5,7 %
- % de narices con lesiones : 100 %
- Puntuación de narices afectadas: 6/20
- Puntuación global : 6/20
Resultados para las primerizas F1 :
- % de pulmones afectados : 15,9 %
- Puntuación para neumonía en pulmones afectados: 6,7/28
- Puntuación global : 1,02/28
- % de pleuresías : 3,5 %
Visita a la explotación
Examen del plan profiláctico:
1. Vacunación de las cerdas:
- Parvovirus : primerizas 2 veces+ vacunación de recuerdo en maternidad
- Mal Rojo: primerizas 2 veces+ vacunación de recuerdo en maternidad
- Rinitis : primerizas 2 veces+ vacunación de recuerdo antes del parto. Se realizó un control inmunitario que mostraba una tasa de anticuerpos antitoxina suficiente en el calostro de primerizas y cerdas.
- Colibacilosis: primerizas 2 veces y vacunación de recuerdo antes del parto.
2. Vacunación de los lechones (comerciales y F1) :
- Micoplasma : 2 inyecciones a los 3 días de vida y en el momento del destete.
Tratamientos actuales:
Lechones destetados (alimento de primera edad) : 120 ppm de colistina y 800 ppm de oxitetraciclina.
Visita a los 2 sitios:
1. Maternidad:
- Primerizas "abuelas" (compra exterior) : sin signos clínicos particulares excepto aparición de tos en la introducción y salida de cuarentena;
- Cerdas (gestación y maternidad) : sin signos clínicos particulares;
- Lechones no destetados: sin signos clínicos particulares;
- Destetes: sin signos clínicos particulares;
- Engorde primerizas F1 : tos pero sin alteración visible del estado general, GMD un 10 % superior a la GMD en el sitio de engorde.
2. Pre-engorde y Engorde (8500 plazas)
- Pre-engorde: tos fuerte pero sin ninguna alteración del estado general. Disminución del índice de crecimiento y aumento de la mortalidad que pasa del 1,5 al 3 %
- Engorde: tos con disnea entre las 4 a 6 semanas tras la llegada pero sin mortalidad característica. Sin signos visibles de rinitis atrófica (desviación nasal , conjuntivitis, …)
En conclusión, presencia de tos pero sin signos clínicos característicos. Se respetan las normas zootécnicas: desinfección, vaciado sanitario, ...
Petición de análisis complementarios
1. Perfil serológico de los cerdos : 23 muestras de sangre (día 1). Análisis a realizar: : Actinobacillus pleuropneumoniae 2 y 1-9-11 + Mycoplasma hyopneumoniae.
2. Contacto con lechones centinela procedentes de la misma explotación que las "abuelas" e indemnes a los principales gérmenes respiratorios. El número se fija en 10 lechones de 70 días de vida que entrarán en contacto al inicio de la fase de engorde con los cerdos de la explotación. El plan de seguimiento de los centinelas es el siguiente:

D0: contacto y toma de muestras de sangre de los centinelas.
A las 3 semanas: toma de muestras de sangre
A las 6 semanas: sacrificio del 50 % de los centinelas para realizar análisis y toma de muestras de sangre
A las 12 semanas: control en matadero de los centinela restantes y toma de muestras de sangre.
En caso de morbilidad, los centinelas se sacrificarán y se realizarán análisis bacteriológicos complementarios.
A la espera de los resultados de los análisis se decide no realizar ningún tratamiento colectivo. Sólo se realizarán cuidados individuales mediante inyección de antibióticos. Se pidió también un control de cada sala en cuanto a ventilación.
Resultado de los análisis
Perfil serológico de los cerdos:
Actinobacillus pleuropneumoniae S2: 0+/23
Actinobacillus pleuropneumoniae S1-9-11: 0+/23
Mycoplasma hyopneumoniae: 2+/23
Perfil serológico, bacteriológico y de lesiones de los centinelas:
| Número | Edad (días) | Necropsia | Muestras de sangre | |
| D 0 | 10 | 70 | 0 | 10 |
| + 3 sem | 9 | 90 | 4 (+1 muertos) | 9 |
| + 6 sem | 5 | 110 | 0 | 5 |
| + 12 sem | 4 | 160 | Matadero (+1 muerto) | 4 |
| D 0 | + 3 sem | + 6 sem | + 12 sem | |
| Micoplasma | 0+/10 | 0+/9 | 0+/5 | 0+/4 |
| Influenza (3 serotipos) | 0+/10 | 0+/9 | 0+/5 | 0+/4 |
| Coronavirus | 2+/10 | 3+/9 | 2+/5 | 2+/4 |
| Actinobacillus 2 y 1-9-11 | 0+/10 | 0+/9 | 0+/5 | 0+/4 |
| Pasteurella multocida (Tox.) | 0+/10 | 0+/9 | 0+/5 | 0+/4 |
![]() |
![]() |
Lesiones sobre un total de 5 necropsias:
- Rinitis marcada (atrofia de los cornetes): 4/5
- Neumonía marcada (10/28): 4/5
- Pleuresía marcada: 3/5
- Abscesos pulmonares: 2/5
- Pericarditis: 1/5
Bacteriología de las lesiones:
1. Lesiones pulmonares:
Actinobacillus pleuropneumoniae B1 S7: 2/4
Pasteurella multocida no toxigénica: 1/4
2. Cornetes nasales:
Haemophilus parasuis: 2/4
Pasteurella multocida no toxigénica: 2/4
Actinobacillus pleuropneumoniae B1 S7: 1/4
Streptococcus suis (1-2): 1/4

Diagnóstico, medidas y evolución
Se deciden realizar serologías del suero de cerdos centinela almacenadas en una sueroteca obteniendo los siguientes resultados:
| D 0 | + 3 sem | + 6 sem | + 12 sem | |
| Actino B1S7 | 0+/10 | 1+/9 | 3+/5 | 4+/4 |
y serología de las cerdas en producción (lactación) : 8+/10
El diagnóstico establecido fue el siguiente:
Pleuroneumonía crónica debida a Actinobacillus pleuropneumoniae Biovar 1 Serovar 7 en asociación con una rinitis atrófica atípica (sin Pasteurella dermotoxigénica y sin Bordetella) la cual se atribuye a la asociación entre Haemophilus parasuis y Pasteurella multocida no toxigénica.
Medidas tomadas (tratamiento y prevención)
Medidas a corto plazo: tras el examen de los antibiogramas, se decidió utilizar oxitetraciclina a una dosis de 50 mg/kg 7 días todas las 8 semanas de engorde.
Medidas a medio plazo:
- Desplazamiento del tratamiento con oxitetraciclina en el pienso de 1ª edad a la entrada en post-destete (pienso de 2ª edad).
- Prueba de vacunación para App en lechones de 8 y 11 semanas.
Medidas a largo plazo: puesta en marcha de la vacunación de los reproductores y animales de reemplazo contra los 3 patógenos aislados: Actinobacillus pleuropneumoniae B1S7, Haemophilus parasuis y Pasteurella multocida.
Evolución sanitaria de la explotación
Los tratamientos antibióticos permitieron al cabo de 6 meses disminuir el impacto de los problemas respiratorios. La vacunación de las cerdas y de las F1 se encuentran en curso y es difícil medir su impacto a corto plazo. Se observó un nuevo empeoramiento del rendimiento de los animales pero esta vez el origen fue sobretodo digestivo y puso en cuestionamiento una nueva utilización de animales centinela para precisar el diagnóstico.
Comentarios
Se trata de una explotación de gran tamaño de ciclo cerrado con problemas respiratorios crónicos.
Este caso da lugar a varios comentarios posteriores.
- El diagnóstico de los problemas respiratorios crónicos en los sitios de gran tamaño de pre-engorde y engorde (ciclo cerrado) da lugar a ciertos problemas para ser suficientemente fiable:
- los signos clínicos fueron a menudo insuficientes o no característicos
- algunas de las necropsias realizadas el día de la visita no fueron suficientes para realizar un diagnóstico.
Una vez realizado el balance técnico, en particular en cuanto al plan de ventilación, fue necesario recurrir a otros métodos. En este caso preciso, se recurrió a 2 métodos diferentes:
1. El perfil serológico para confirmar una hipótesis;
2. El contacto con cerdos centinela para "seleccionar" los patógenos "activos". Esta técnica conocida en estaciones experimentales utiliza cerdos SPF, cosa imposible en la explotación. La solución de utilizar cerdos del mismo origen que los reproductores procedentes de una explotación con estatus sanitario conocido representa un método práctico.
Estos dos métodos permitieron poner en evidencia y confirmar una patología debida a Actinobacillus pleuropneumoniae Biovar 1 Serovar 7 la virulencia del cual fue suficiente para ocasionar problemas respiratorios crónicos caracterizados por causar problemas en el crecimiento y lesiones de pleuresía.
Por contra, respecto al diagnóstico de la rinitis atípica constatada en los centinelas (ausencia de Pasteurella dermotoxinogénica y transmisión horizontal en los animales de más de 70 días), en aquel momento faltó una herramienta de diagnóstico fiable. En al actualidad mediante la utilización de escobillones nasales analizados con una PCR Pasteurella multocida dermotoxinogénica se hubiera podido confirmar el diagnóstico.
- El caso muestra también el problema de la circulación de Actinobacillus pleuropneumoniae en los reproductores.
- ¿Esta circulación es primaria o secundaria en relación con la existente en el engorde?
- ¿Cómo erradicarlo?
La combinación del destete precoz de las futuras F1 (14 d) junto con la utilización de un sitio separado para el crecimiento y preparación de las primerizas cubiertas podrá ser una opción interesante.
- La última reflexión a la que nos lleva este caso sería el interés de una vacunación específica de los reproductores para llegar a corto o medio plazo a parar la circulación en éstos animales, a homogeneizar el estatus inmunitario de los lechones y decidir a largo plazo la profilaxis antibiótica o vacunal sobre los cerdos de crecimiento-engorde.
Aunque este método es imperfecto, parece ser un buen intermediario entre la utilización "regular" de los antibióticos en engorde y la erradicación a menudo difícil de poner en marcha.